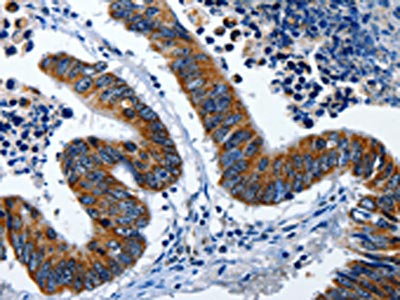

LAMA1 Antibody
-
中文名稱:LAMA1兔多克隆抗體
-
貨號:CSB-PA194222
-
規格:¥1100
-
圖片:
-
The image on the left is immunohistochemistry of paraffin-embedded Human colon cancer tissue using CSB-PA194222(LAMA1 Antibody) at dilution 1/25, on the right is treated with synthetic peptide. (Original magnification: ×200)
-
The image on the left is immunohistochemistry of paraffin-embedded Human lung cancer tissue using CSB-PA194222(LAMA1 Antibody) at dilution 1/25, on the right is treated with synthetic peptide. (Original magnification: ×200)
-
-
其他:
產品詳情
-
Uniprot No.:
-
基因名:
-
別名:LAMA1 antibody; LAMA antibody; Laminin subunit alpha-1 antibody; Laminin A chain antibody; Laminin-1 subunit alpha antibody; Laminin-3 subunit alpha antibody; S-laminin subunit alpha antibody; S-LAM alpha antibody
-
宿主:Rabbit
-
反應種屬:Human
-
免疫原:Synthetic peptide of Human LAMA1
-
免疫原種屬:Homo sapiens (Human)
-
標記方式:Non-conjugated
-
抗體亞型:IgG
-
純化方式:Antigen affinity purification
-
濃度:It differs from different batches. Please contact us to confirm it.
-
保存緩沖液:-20°C, pH7.4 PBS, 0.05% NaN3, 40% Glycerol
-
產品提供形式:Liquid
-
應用范圍:ELISA,IHC
-
推薦稀釋比:
Application Recommended Dilution ELISA 1:1000-1:5000 IHC 1:25-1:100 -
Protocols:
-
儲存條件:Upon receipt, store at -20°C or -80°C. Avoid repeated freeze.
-
貨期:Basically, we can dispatch the products out in 1-3 working days after receiving your orders. Delivery time maybe differs from different purchasing way or location, please kindly consult your local distributors for specific delivery time.
-
用途:For Research Use Only. Not for use in diagnostic or therapeutic procedures.
相關產品
靶點詳情
-
功能:Binding to cells via a high affinity receptor, laminin is thought to mediate the attachment, migration and organization of cells into tissues during embryonic development by interacting with other extracellular matrix components.
-
基因功能參考文獻:
- We report here a severe defect of neuromuscular transmission in a consanguineous patient with a homozygous variant in the laminin alpha-5 subunit gene (LAMA5). The variant c.8046C>T (p.Arg2659Trp) is rare and has a predicted deleterious effect. The affected individual, who also carries a rare homozygous sequence variant in LAMA1, had muscle weakness, myopia, and facial tics PMID: 28544784
- LAMA1 SNP rs2089760 plays an important role in the development of PM. PMID: 26862816
- LAMA1 deficiency can lead to alteration in cytoskeletal dynamics, which may invariably lead to alteration in dendrite growth and axonal formation. Patient-derived fibroblasts have impaired adhesion, reduced migration, abnormal morphology and increased apoptosis due to impaired activation of Cdc42, a member of the Rho family of GTPases that is involved in cytoskeletal dynamics. PMID: 27095636
- Sixteen novel LAMA1 variants were identified in fourteen families with Poretti-Boltshauser syndrome. The frameshift variant c.[2935delA] recurred in six unrelated families on a shared haplotype, suggesting a founder effect. PMID: 26932191
- Taken together, these findings suggest that miR-202 may function as a novel tumor suppressor in ESCC by repressing cell proliferation and migration, and its biological effects may attribute the inhibition of LAMA1-mediated FAK-PI3K-Akt signaling. PMID: 27045085
- Laminins are involved in genetic and acquired bullous dermatoses, and collagenoses. PMID: 27464450
- Studies of the hLM alpha-1N C49S mutant show that this mutation causes enhanced self-association behavior, which can explain the inability of laminin bearing this mutation to fulfill functional roles in vivo. PMID: 26215696
- Our results indicate that invasion of cervical cancer is accomplished by the remodeling of the interstitial stroma, which process includes decrease and partial replacement of fibronectin and collagens by a laminin-rich matrix PMID: 25885552
- Novel PMCA3 missense mutation co-occurring with a heterozygous mutation in LAMA1 impaired cellular Ca2+ homeostasis in patients with Cerebellar Ataxia. PMID: 25953895
- skin-processed peptides play role in wound healing and antimicrobial response PMID: 24458132
- Identification of biallelic mutations in LAMA1 as the cause of cerebellar dysplasia with cysts in seven affected individuals. PMID: 25105227
- Studies indicate that progenitor endothelial cells (ECs), endothelial colony-forming cells (ECFCs), deposit collagen IV, fibronectin, and laminin. PMID: 22919069
- miR-9 negatively controls lamin A and progerin expression in neural cells. PMID: 22840390
- we report associations with the LAMA1 and HMG20A (not previously associated at genome-wide significance in Europeans) gene regions with type 2 diabetes risk PMID: 22693455
- Laminin-alpha1 LG4-5 domain binding to dystroglycan mediates muscle cell survival, growth, and the AP-1 and NF-kappaB transcription factors but also has adverse effects. PMID: 22159078
- The polymorphism of SNP rs2089760, located in the promoter region of LAMA1, may be associated with high myopia in the Chinese population. PMID: 21541277
- c-Jun/AP-1 activity mediated by JNK, PI3K/Akt and ERK pathways is required for laminin-1-induced neurite outgrowth in human bone marrow mesenchymal stem cells. PMID: 21570970
- Abnormal distribution of laminin alpha1 and laminin alpha5 in glomerular basement membrane is correlated with GBM thickening and splitting in human Alport's syndrome. PMID: 20019771
- Observational study of gene-disease association. (HuGE Navigator) PMID: 19913121
- Observational study of gene-disease association, gene-environment interaction, and pharmacogenomic / toxicogenomic. (HuGE Navigator) PMID: 20628086
- Clinical trial of gene-disease association and gene-environment interaction. (HuGE Navigator) PMID: 20379614
- Laminin-derived peptide AG73 regulates migration, invasion, and protease activity of human oral squamous cell carcinoma cells through syndecan-1 and beta1 integrin. PMID: 20237901
- Exposure of cryptic domains in the alpha 1-chain of laminin-1 by elastase stimulates macrophages urokinase and matrix metalloproteinase-9 expression. PMID: 11827968
- Alpha 1 laminin was heavily over-expressed in Alzheimer disease frontal cortex, and localized in reactive astrocytes of the grey and white matter, and as punctate deposits in the senile placques of the Alzheimer brain tissue. PMID: 12111806
- Laminins with alpha1, alpha4, and alpha5 chains are compared to determine laminin isoform-specific promotion of adhesion and migration of human bone marrow progenitor cells. PMID: 12393739
- mRNA encoding laminin-alpha1, -beta1, and -gamma1 chains was expressed in 90% of endometriotic lesions. PMID: 12615822
- adhesion to laminin-1 through alpha6-integrin represents a protective mechanism for melanocytes to withstand UVB damage PMID: 15885076
- analysis of structure and activities reveal differences in laminin G-like domain interactions that should enable dissection of biological roles of different laminin ligands PMID: 17307732
- analysis of how distinct acidic clusters and hydrophobic residues in the alternative splice domains X1 and X2 of alpha7 integrins define specificity for laminin isoforms PMID: 17618648
- Real-time PCR showed that ETOH significantly altered the expression of genes involved in cell adhesion. There was an increase in the expression of alpha and beta Laminins 1, beta Integrins 3 and 5, Secreted phosphoprotein1 and Sarcoglycan epsilon. PMID: 18162078
- Subepicardial localization of CD117-positive cells and expression of laminin-1 and alpha(6) integrin subunits may all correspond to the activation of regeneration involving an epithelial-mesenchymal transition in adult heart PMID: 18436868
- The laminin and laminin gene expression was higher in the aganglionic segment than in the dilated segment, and the expression decreased stepwisely from the aganglionic segment to the normal segment. PMID: 18661771
- laminin-111 (alpha(1), beta(1), gamma(1)), which is expressed during embryonic development but absent in normal or dystrophic skeletal muscle, increased alpha(7)-integrin expression in mouse and DMD patient myoblasts PMID: 19416897
- These results identify a previously undescribed role of carbohydrate-dependent cell-basement membrane interaction in tumor suppression and its control by beta3GnT1 and LARGE. PMID: 19587235
- Promoter -1030C/T polymorphism of LMNA is a possible genetic predisposition to arterial stiffness in the Japanese population PMID: 19672032
- Clinical trial and genome-wide association study of gene-disease association, gene-environment interaction, and pharmacogenomic / toxicogenomic. (HuGE Navigator) PMID: 18519826
顯示更多
收起更多
-
相關疾病:Poretti-Boltshauser syndrome (PTBHS)
-
亞細胞定位:Secreted, extracellular space, extracellular matrix, basement membrane. Note=Major component.
-
數據庫鏈接:
Most popular with customers
-
-
YWHAB Recombinant Monoclonal Antibody
Applications: ELISA, WB, IHC, IF, FC
Species Reactivity: Human, Mouse, Rat
-
-
-
-
-
-